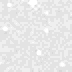

Mars Pathfinder IMP Image I855039L.IMG
COMMAND SEQUENCE #35: NIGHTTIME OPACITY

Click to download full resolution PDS image:
sky/seq0035/c1247xxx/i855039l.img
|
|
|
|
PDS Label Parameters
|
|
|
|
| Product Id | IMP_EDR-1247855039-REGULAR-0035100008 | ||
| Target Name | SKY | Instrument Deployment State | DEPLOYED |
| Image Time | 1997-07-17T18:23:54.230Z | Azimuth Motor Clicks | 437 |
| Planet Day Number | 13 | Elevation Motor Clicks | 295 |
| MPF Local Time | 20:04:37 | Instrument Azimuth | 328.4510 |
| Frame ID | LEFT | Instrument Elevation | 67.0510 |
| Exposure Duration | 32767.0000 | Surface Based Inst. Azimuth | 115.3390 |
| Filter Name | L860_R-DIOPTER | Surface Based Inst. Elevation | 66.5034 |
| Filter Number | 7 | Solar Azimuth | 293.9120 |
| Inst. Cmprs. Ratio | 18.3396 | Solar Elevation | -23.9663 |
| Observation Name | NIGHTTIME_OPACITY.7CMD | ||